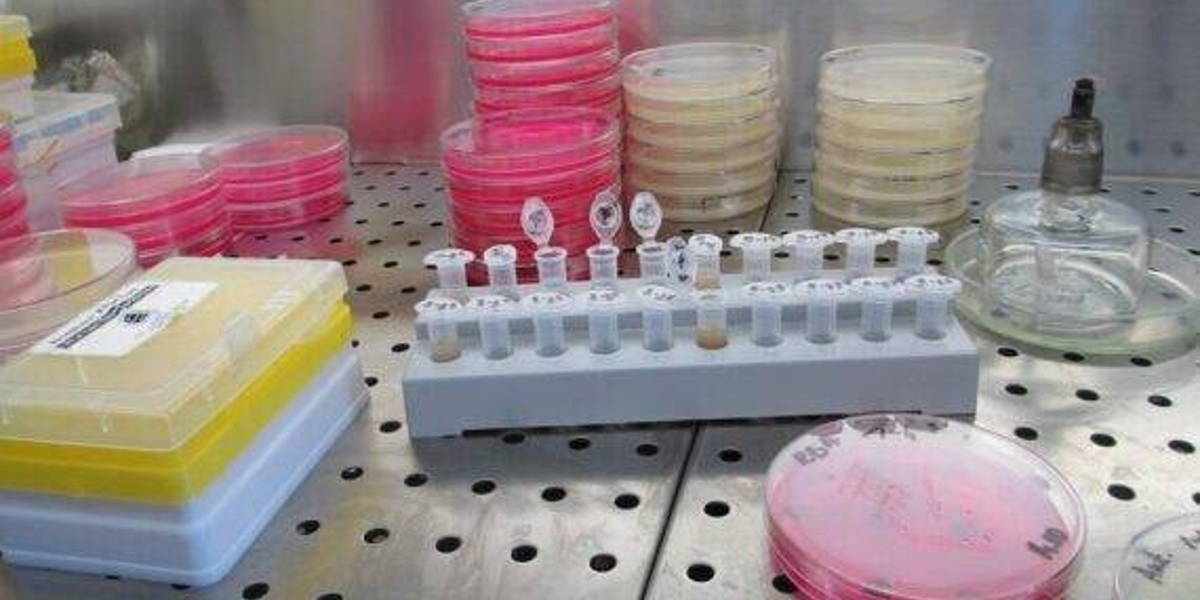
Laboratorium-2-570x360-1

Wetenschappers van Radboudumc en Radboud Universiteit gaan twee grote onderzoeksprojecten leiden met Perspectief-subsidies van NWO. Het gaat om een onderzoek onder leiding van Frank Nijssen naar optimale bestraling van tumoren van binnenuit met radioactieve stoffen. Het tweede gehonoreerde onderzoek onder leiding van Johan Kwisthout gaat over het inzetten van AI om de optimale individuele behandeling van kanker vast te stellen.
Beide door Perspectief gehonoreerde projecten hebben als doel het verbeteren van de behandeling van kanker. Aan de projecten doen ook tal van andere actoren zoals bedrijven, maatschappelijke organisaties en overheden mee. Perspectief is een programma van de Nederlandse Organisatie voor Wetenschappelijk Onderzoek (NWO), gefinancierd door het ministerie van Economische Zaken en Klimaat (EZK). Dit jaar is een totaal budget van 27 miljoen beschikbaar, waarvan 23 miljoen van EZK en 4 miljoen euro van het ministerie van Onderwijs, Cultuur en Wetenschap.
Radioactieve stoffen bestralen van binnenuit
Het project van dr. Frank Nijssen van Radboudumc is gedoteerd met 5,3 miljoen euro. In dit onderzoek wordt bekeken of de overlevingskansen van patiënten met uitgezaaide kanker kunnen worden verbeterd. Concreet gaat het om zogeheten radionuclidentherapie. Bij deze therapie krijgen patiënten een radioactieve stof, het radionuclide, ingespoten. Deze stoffen zoeken de tumoren in het lichaam op en bestralen ze vervolgens lokaal van binnenuit.
Het UNRANU-programma onderzoekt nieuwe methodes om radionucliden te produceren, welke radionucliden het beste werken voor welke tumortypes, welke dosis daarbij optimaal is en op welke manier het immuunsysteem de effectiviteit van de behandeling beïnvloedt. Frank Nijssen vertelt op de website van Radboudumc: “We gaan met de subsidie samen met ketenpartners tumorcellen en organoïden onderzoeken. Tevens ontwikkelen we tumormodellen. Zo willen we zicht krijgen op hoe radioactieve stof de tumorcellen precies doodt”
Individuele kankerbehandeling met AI
Bij het tweede project van dr. Johan Kwisthout gaat het om een meer gepersonaliseerde behandeling van kanker. Het onderzoek wordt gedoteerd met 4,5 miljoen euro in het kader van Perspectief. Nog vaak wordt er gekozen voor een standaardbehandeling, waarbij geen rekening wordt gehouden met de verwachtingen van de patiënt omtrent de resulterende kwaliteit van leven.
Kwisthout en zijn onderzoeksteam gaan met AI-gestuurde software, het PersOn-programma, zoeken naar de optimale behandeling voor de individuele patiënt. Het PersOn-programma analyseert met behulp van kunstmatige intelligentie alle beschikbare gegevens over het type kanker en de individuele patiënt en voorspelt daarmee het te verwachten behandelresultaat. Met deze informatie kunnen arts en patiënt samen kiezen voor het zorgtraject dat voor die persoon met de grootste waarschijnlijkheid de beste kwaliteit van leven zal opleveren.